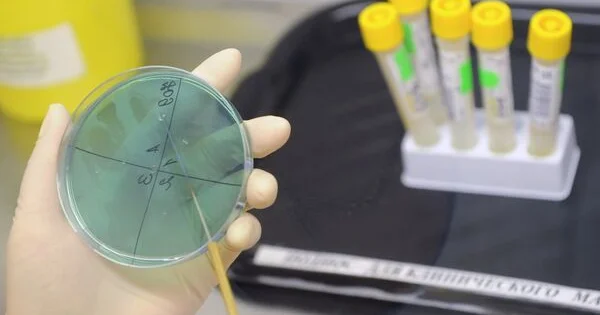

Türkiyəyə sığınan suriyalılar ölkələrinə qayıdır
Ses qazeti portalından verilən məlumata əsasən, Icma.az bildirir.
Ölkələrində gedən vətəndaş müharibəsi zamanı Türkiyəyə sığınan suriyalılar 61 illik Baas hakimiyyətinin devrilməsindən sonra Suriyaya qayıtmaq üçün Türkiyənin Hatay vilayətində yerləşən Cilvegözü sərhəd keçid məntəqəsinə axışıblar. SİA-nın məlumatına görə, suriyalılar səhər saatlarından Reyhanlı rayonundakı sərhəd keçid məntəqəsində növbəyə düzülərək gömrük prosedurlarını gözləyiblər.
Suriyalılardan Adem Muhammed Zin məmləkəti Dəməşqə getmək üçün yola düşdüklərini bildirib.
Uzun illərdən sonra ölkələrinin azad olunmasını alqışladıqlarını bildirən Zin "Yolumuz açıldı, Əsəd getdi, müharibə bitdi. 10 il İstanbulda oldum. Allah türklərdən razı olsun, bizə çox kömək etdilər" deyib
Əli Hasiko isə 12 ildir ki, doğma şəhəri Həmaya qayıtmağı gözlədiklərini bildirib.
Türkiyəyə təşəkkürünü bildirən Hasiko "Qapılarını üzümüzə açdığı üçün Türkiyəyə təşəkkür edirəm" deyib.
İbrahim Əl Muta da 6 nəfərlik ailəsi ilə Həmaya getməyi gözlədiklərini bildirib.
Təxminən 11 ildir Türkiyədə olduqlarını bildirən Əl Muta "Allaha şükür müharibə bitdi. Türkiyə çox gözəldir, amma bizim vətənimiz Suriyadır" deyib.
Baxış sayı:114
Bu xəbər 09 Dekabr 2024 23:54 mənbədən arxivləşdirilmişdir



Daxil ol
Xəbərlər
Hava
Maqnit qasırğaları
Namaz təqvimi
Qiymətli metallar
Valyuta konvertoru
Kredit Kalkulyatoru
Kriptovalyuta
Bürclər
Sual - Cavab
İnternet sürətini yoxla
Azərbaycan Radiosu
Azərbaycan televiziyası
Haqqımızda
Əlaqə
TDSMedia © 2025 Bütün hüquqlar qorunur







Günün ən çox oxunanları